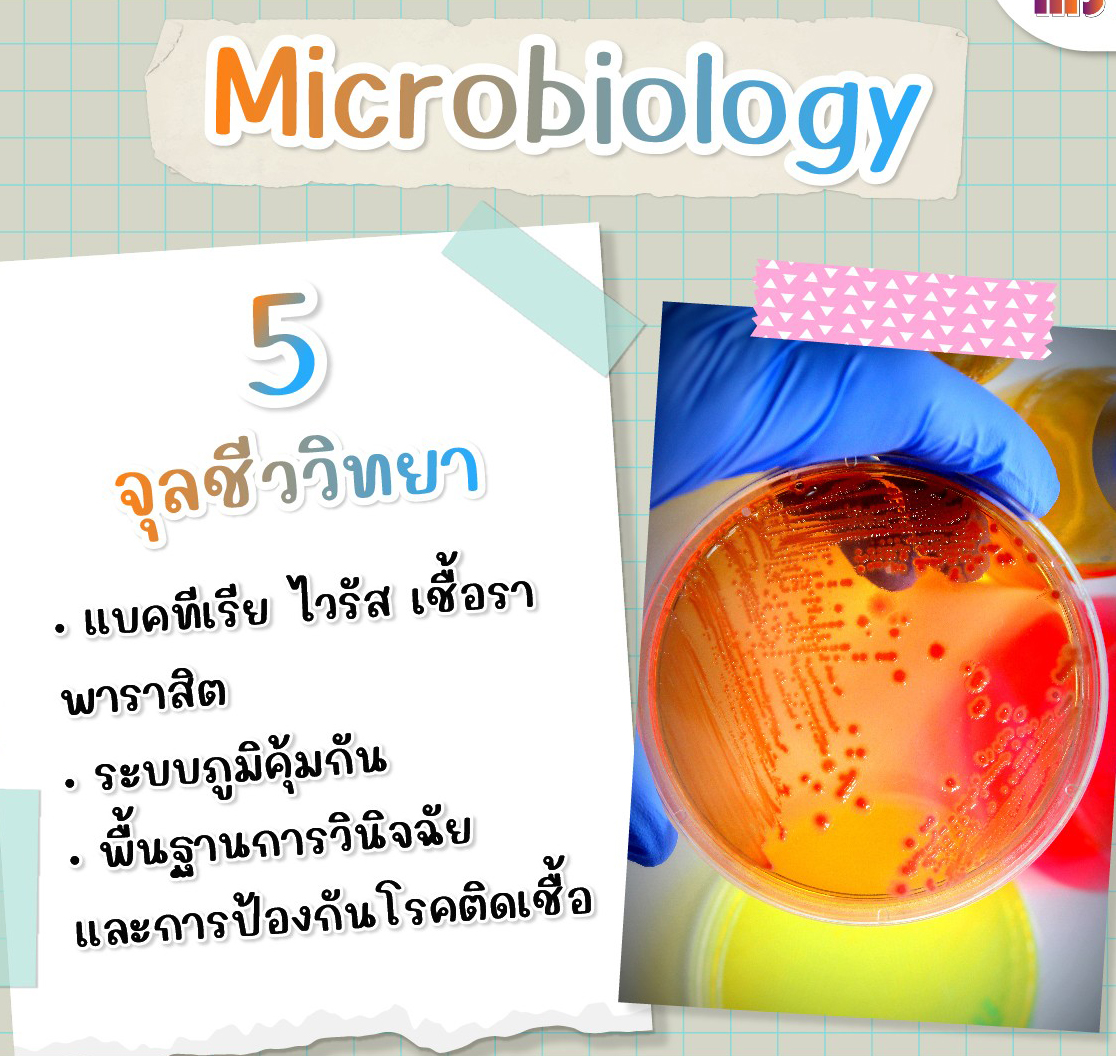

เจาะลึก 6 วิชาหลักที่ออกสอบแน่นอน
- Anatomy (กายวิภาคศาสตร์) ท่องให้แม่นตั้งแต่โครงสร้าง อวัยวะ ระบบกล้ามเนื้อ ไปจนถึงเส้นประสาทสำคัญๆ
- Physiology (สรีรวิทยา) เข้าใจกลไกการทำงานของร่างกาย ระบบหัวใจ ทางเดินหายใจ และการรักษา Homeostasis
- Biochemistry (ชีวเคมี) เน้น Metabolism ของสารอาหาร เอนไซม์ วิตามิน และฮอร์โมน (จุดเก็บคะแนนที่ห้ามพลาด!)
- Pathology (พยาธิวิทยา) เข้าใจการเปลี่ยนแปลงของเซลล์ กลไกการเกิดโรค และการตอบสนองต่อการบาดเจ็บ
- Microbiology (จุลชีววิทยา) รู้จักเชื้อโรคทุกประเภท แบคทีเรีย ไวรัส เชื้อรา ปรสิต และระบบภูมิคุ้มกัน
- Pharmacology (เภสัชวิทยา) กลไกการออกฤทธิ์ของยาและผลข้างเคียงที่ต้องระวัง
!!ลักษณะข้อสอบที่ต้องเตรียมรับมือ!!
- เป็นข้อสอบปรนัย (MCQ) ทั้งหมด ประมาณ 200 ข้อ
- ให้เวลาสอบ 4 ชั่วโมง (เฉลี่ยข้อละไม่ถึง 2 นาที!)
- เกณฑ์ผ่านคือต้องได้ ≥ 60%
เส้นทางนี้อาจจะเหนื่อย แต่ถ้าเตรียมตัวดี มีชัยไปกว่าครึ่ง!


การสอบ NL1 (National License Step 1) ไม่ใช่แค่การสอบธรรมดา แต่คือการพิสูจน์ "ฐานราก" ความรู้พรีคลินิกที่เราเรียนมา
เจาะลึก 6 วิชาหลักที่ออกสอบแน่นอน
- Anatomy (กายวิภาคศาสตร์) ท่องให้แม่นตั้งแต่โครงสร้าง อวัยวะ ระบบกล้ามเนื้อ ไปจนถึงเส้นประสาทสำคัญๆ
- Physiology (สรีรวิทยา) เข้าใจกลไกการทำงานของร่างกาย ระบบหัวใจ ทางเดินหายใจ และการรักษา Homeostasis
- Biochemistry (ชีวเคมี) เน้น Metabolism ของสารอาหาร เอนไซม์ วิตามิน และฮอร์โมน (จุดเก็บคะแนนที่ห้ามพลาด!)
- Pathology (พยาธิวิทยา) เข้าใจการเปลี่ยนแปลงของเซลล์ กลไกการเกิดโรค และการตอบสนองต่อการบาดเจ็บ
- Microbiology (จุลชีววิทยา) รู้จักเชื้อโรคทุกประเภท แบคทีเรีย ไวรัส เชื้อรา ปรสิต และระบบภูมิคุ้มกัน
- Pharmacology (เภสัชวิทยา) กลไกการออกฤทธิ์ของยาและผลข้างเคียงที่ต้องระวัง
!!ลักษณะข้อสอบที่ต้องเตรียมรับมือ!!
- เป็นข้อสอบปรนัย (MCQ) ทั้งหมด ประมาณ 200 ข้อ
- ให้เวลาสอบ 4 ชั่วโมง (เฉลี่ยข้อละไม่ถึง 2 นาที!)
- เกณฑ์ผ่านคือต้องได้ ≥ 60%
เส้นทางนี้อาจจะเหนื่อย แต่ถ้าเตรียมตัวดี มีชัยไปกว่าครึ่ง!